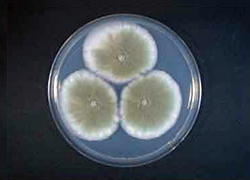

Develop
開発
高度な研究開発力が生み出す、機能素材
DAIYUの先進技術を幅広い分野で活用する為にここでは、靴の研究・開発をはじめ、素材の機能・物性試験や一般微生物試験、抗菌・抗カビ試験,消臭試験など、環境や各種工業製品等の汚染劣化微生物の研究を中心とした様々な試験研究活動を行っています。自社の研究・開発はもちろん、他社からの試験依頼にも正確且つ迅速に対応しており、試験研究機関として高い評価を受けています。



-
快適な靴環境のために
履く人全体重を支える役目を担う靴の素材には、強度や機能面において厳しい条件と高い品質性が求められます。
独自の研究機関を有するDAIYUでは、その高度な開発技術を駆使して、ユーザー利用環境・使用条件をあらゆる角度からシュミレートし、どのような状況下においても高い快適性を実現する機能素材を開発、心地よい靴環境の創造を追及しています。 -
ユーザーニーズを先取りする商品開発
「機能を科学する」という開発コンセプトをもとに、DAIYUでは、独自の研究開発はもちろん、原料メーカー、シューズメーカーとの共同開発を通じて、数多く画期的な機能素材、加工技術および製品を生み出してきました。吸水性、通気・透湿性に優れた機能性人工皮革、消臭、抗菌防臭、防カビ機能を備えた「オーダレス®」。また、環境配慮型のエコロジー機能素材など、ユーザーニーズを先取りした画期的な商品を開発し、高い信頼・評価を受けています。DAIYU独自の機能素材を使用し、ユーザーの求める独創的な商品提供が可能です。
国内生産を中心にインソールや各パーツを、海外を拠点にオリジナル性の高いカップインソールなどの生産及び商品開発を行っております。
研究開発室
DAIYUの先進技術を幅広い分野で活用する為にここでは、靴の研究・開発をはじめ、素材の機能・物性試験や一般微生物試験、抗菌・抗カビ試験、消臭試験などを中心とした様々な試験研究活動を行っています。
靴の研究・開発
●靴素材の機能・物性試験


衛生・微生物研究
●一般微生物試験一般生菌数測定/カビの分離・同定
●消臭加工製品の消臭効果試験